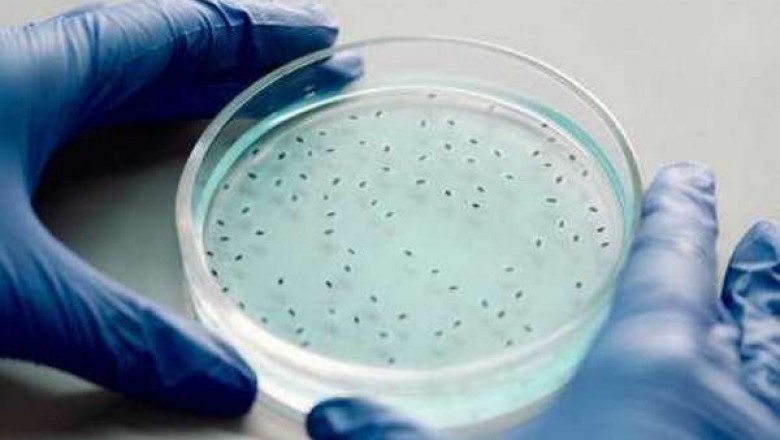

views
The HPAPIs and cytotoxic drugs fabricating extremity free security tests have been created by a few drug organizations. These substance specialists are needed to be kept beneath the security standards determined by the US Food and Drug Administration (FDA). Nonetheless, the current wellbeing rules distributed by the FDA do exclude these drugs. As indicated by the FDA, these mixtures are not considered reasonable for the assembling of immunizations or therapies for disease. Makers are not needed to remember the drugs for their items except if they are now named as safe for use by the FDA. To guarantee the wellbeing of these compound specialists, makers need to agree with the rules distributed by the FDA. The quest for exceptionally powerful dynamic drug fixings has gotten one of the significant themes among corrective producers and medical services suppliers.
With new exploration being played out constantly, organizations are continually searching for new specialists that can battle against genuine medical problems. Demonstrated to be powerful in the battle against irresistible sicknesses like HIV/AIDS, these fixings can likewise assist with less genuine medical conditions. Indeed, these fixings can even fix disease. The marking of HPAPIs and cytotoxic medication producing is important to guarantee the wellbeing of these compound substances. This will guarantee that the patient utilizing the medication won't foster any unfavorably susceptible response to it. This is significant in light of the fact that some medicine related antagonistic occasions have been accounted for. The patient may foster anaphylactic shock in the event that he breathes in the medication airborne during an asthma assault. Moreover, the patient may foster lung or liver issues on the off chance that he is presented to poisonous drugs during the assembling interaction. The toxicology contemplates led to understand the unfavorable impacts of HPAPIs and cytotoxic drugs were directed on creatures.
These examinations uncovered that openness to high portions of these synthetic compounds can prompt the development of kidney cell tumors. This happens on the grounds that these drugs are processed in the kidneys, which are organs that line the veins providing the organs. On the off chance that these drugs are not fabricated with wellbeing measures, this may prompt calamitous wellbeing issues. The HPAPIs and cytotoxic medication producing cycle ought to likewise be made viable with human cell societies. This will help in boosting the proficiency and diminishing the expense of creating these drugs. Producers should put forth attempts to keep up with the nature of the crude materials, perform proper weakening advances, and right any pollution issues. This will work on the nature of the eventual outcome and limit wellbeing dangers brought about by drug fabricating.
Cytotoxic drugs are profoundly poisonous. Subsequently, the handling of these harmful specialists is extremely hazardous and even prompts lethal results if not as expected handled. These drugs contain poisonous specialists that can end up being lethal when presented to and consumed by the skin. Truth be told, they likewise cause sensitivities, malignant growth and numerous other wellbeing problems. Accordingly, drug engineers should be knowledgeable with the dangerous impacts of cytotoxic drugs and should do whatever it takes to configuration, production and handle them in an exceptionally protected way.
Read More @ https://coherentmarketinsights-market.blogspot.com/2021/04/manufacturing-hpapis-and-cytotoxic.html
For More Information @ https://www.openpr.com/news/2121836/hpapis-and-cytotoxic-drugs-manufacturing-market-2020-global












